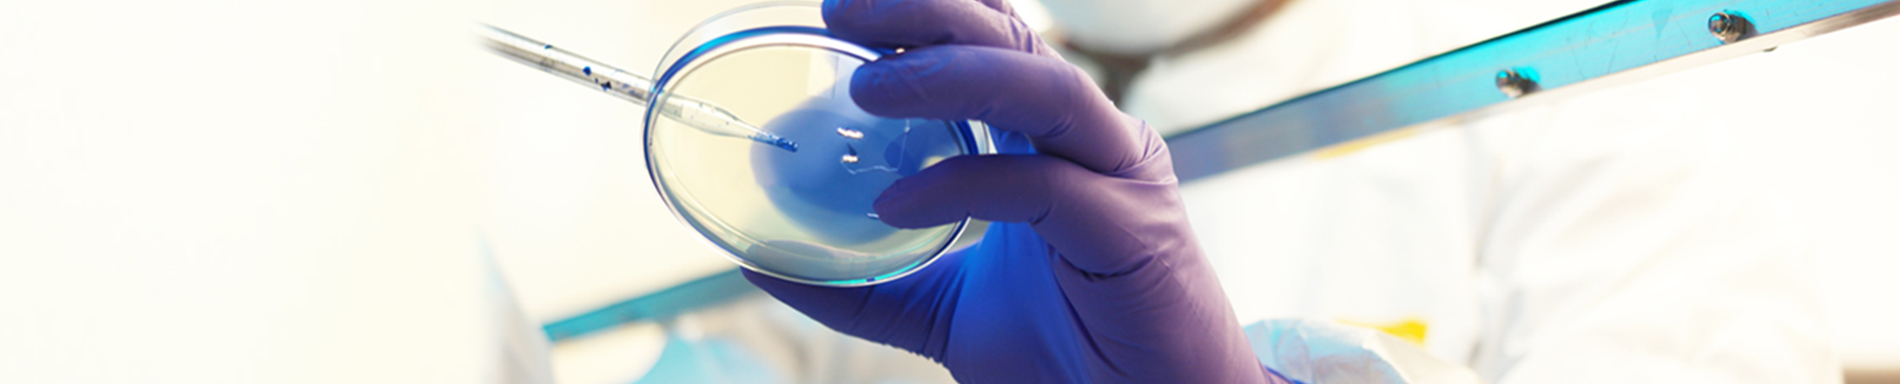
imagen

Infectología Adulto
La Infectología es una subespecialidad de la medicina interna que se dedica al estudio y tratamiento de las enfermedades producidas por agentes infecciosos como virus, bacterias, parásitos y hongos. Además, se ocupa de temas relacionados con patologías infecciosas como el VIH, síndromes febriles, enfermedades virales crónicas, infecciones vinculadas a patologías tropicales, manejo de brotes epidémicos y racionalización en el uso de antibióticos.
El área de infectología de Clínica Alemana Temuco destaca en la incorporación de nuevas tecnologías de diagnóstico de infecciones entéricas y respiratorias, además de contar con la posibilidad de hacer pruebas a nivel molecular con carga viral, único en la zona sur.